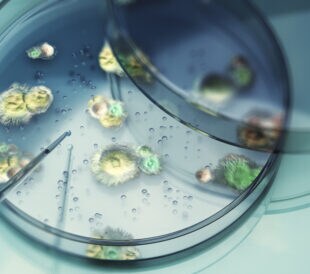
3d Render Testing Liquid from Glass Pipette to Moldy Fungi in Petri Dish on Reflective Background, Laboratory and Medical Concept (Depth Of Field)

In Asia, the medicinal herb and dietary supplement Radix Astragali enjoys a solid and longstanding reputation for its antioxidative, anti inflammatory, antitumoral, antiviral, immunostimulant, and hepatoprotective properties.1,2,3,4 While previous researchers identified isoflavonoids and astragalosides as the major active metabolites of the herb, inadequate information exists on its biochemical structure. Recently, Zhang et al.5 used magnetic solid phase fishing and off-line two-dimensional high-performance liquid chromatography-diode array detection multiple stage mass spectrometry (2D HPLC–DAD–MSn) with size exclusion chromatography (SEC) followed by radical probe (RP) mass spectrometry (Thermo Scientific) to complete the first systematic analysis of human serum albumin (HSA) binders in Radix Astragali. This examination arose as part of a continuing project to create rapid screening protocols for the identification of bioactive compounds in natural products. Using this method, the researchers identified or inferred 47 biologically active compounds in Radix Astragali, including 34 isoflavonoids and 13 astragalosides. The team made tentative identifications based on solid factors, including retention time, molecular weight, comparison with diagnostic fragment ions, and ultraviolet signatures. In general, isoflavones (compounds 1-4, 6-18, 21, 23, 25, 27, 33, 34, 38) presented a maximum absorbance near 260 nm and a second peak between 290 and 320 nm. Astragalosides (compounds 29, 30, 32, 35-37, 39, 42-47) demonstrated weak ultraviolet peaks at 280 nm. Both isoflavans and pterocarpans (compounds 5, 19, 20, 22, 24, 26, 28, 31, 40, 41) showed maximum absorption at 280 nm. The researchers explained that instances of higher molecular weight most likely indicated glycosylation. Overall, Zhang et al. found their method provides a sensitive, reliable alternative that offers effective, rapid bioprofiling of even complex mixtures in a decidedly convenient manner. The protocol may be especially useful for researchers working with compounds that contain overlapping or low abundance components or who seek an approach that does not require separate purification steps. References
In Asia, the medicinal herb and dietary supplement Radix Astragali enjoys a solid and longstanding reputation for its antioxidative, anti inflammatory, antitumoral, antiviral, immunostimulant, and hepatoprotective properties.1,2,3,4 While previous researchers identified isoflavonoids and astragalosides as the major active metabolites of the herb, inadequate information exists on its biochemical structure. Recently, Zhang et al.5 used magnetic solid phase fishing and off-line two-dimensional high-performance liquid chromatography-diode array detection multiple stage mass spectrometry (2D HPLC–DAD–MSn) with size exclusion chromatography (SEC) followed by radical probe (RP) mass spectrometry (Thermo Scientific) to complete the first systematic analysis of human serum albumin (HSA) binders in Radix Astragali. This examination arose as part of a continuing project to create rapid screening protocols for the identification of bioactive compounds in natural products. Using this method, the researchers identified or inferred 47 biologically active compounds in Radix Astragali, including 34 isoflavonoids and 13 astragalosides. The team made tentative identifications based on solid factors, including retention time, molecular weight, comparison with diagnostic fragment ions, and ultraviolet signatures. In general, isoflavones (compounds 1-4, 6-18, 21, 23, 25, 27, 33, 34, 38) presented a maximum absorbance near 260 nm and a second peak between 290 and 320 nm. Astragalosides (compounds 29, 30, 32, 35-37, 39, 42-47) demonstrated weak ultraviolet peaks at 280 nm. Both isoflavans and pterocarpans (compounds 5, 19, 20, 22, 24, 26, 28, 31, 40, 41) showed maximum absorption at 280 nm. The researchers explained that instances of higher molecular weight most likely indicated glycosylation. Overall, Zhang et al. found their method provides a sensitive, reliable alternative that offers effective, rapid bioprofiling of even complex mixtures in a decidedly convenient manner. The protocol may be especially useful for researchers working with compounds that contain overlapping or low abundance components or who seek an approach that does not require separate purification steps. References
- Chu, C. et al. (2010). ‘Characterization of novel astragaloside malonates from Radix Astragali by HPLC with ESI quadrupole TOF MS.’ Journal of Separation Science, 33, 570–581.
- Huang, X. et al. (2009) ‘Studies on principle components and antioxidant activity of different Radix Astragali samples using high-performance liquid chromatography/electrospray ionization multiplestage tandem mass spectrometry.’ Talanta, 78, 1090–1101.
- Lau, K. M. et al (2012). ‘Synergistic interaction between Astragali Radix and Rehmanniae Radix in a Chinese herbal formula to promote diabetic wound healing’. Journal of Ethnopharmacology, 141, 250–256.
- Qi, L. W. et al. (2008). ‘Qualitative and quantitative analysis of Radix Astragali products by fast high-performance liquid chromatography-diode array detection coupled with time-of-flight mass spectrometry through dynaminc adjustment of fragment voltage.’ Journal of Chromatography A, 1203, 27–35.
- Zhang, Y. et al. (2014) ‘Integration of magnetic solid phase fishing and off-line two-dimensional high-performance liquid chromatography–diode array detector–mass spectrometry for screening and identification of human serum albumin binders from Radix Astragali.’ Food Chemistry, 146, 56–64.

Leave a Reply